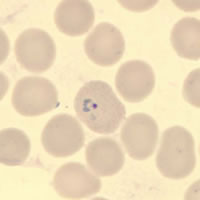
Case 97 Image B
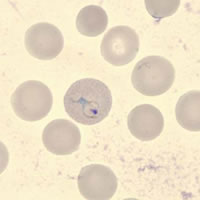
Case 97 Image C
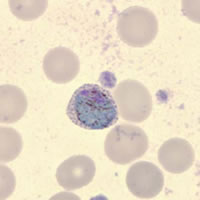
Case 97 Image D

|
Case 97:
A 30-year-old woman traveled to Honduras last year. She did not
take malaria prophylaxis. Since returning from her trip, she has
experienced symptoms that included fever, chills, and headache. A
blood sample was collected, smears were made and stained with Giemsa,
and sent to the Tennessee Department of Health Laboratory Services. Below
are images from her blood smears. What is your diagnosis? Based
on what criteria?
 |
|
| A |
B |
|
|
| C |
D |
Acknowledgement:
The case history and images were kindly provided by the Tennessee Department
of Health Laboratory Services.
Click
here for the answer to Case 97.
Case
98:
A 5-year-old girl developed an earache after vacationing in Belize with
her parents. A few months after returning from the vacation, her
parents took her to a New York City hospital for the earache where a biopsy
specimen was taken from her left ear. Her parents reported that
she had gone swimming during the trip. The following images
are from H & E (hematoxylin and eosin) stained sections of the biopsy. What
is your diagnosis? Based on what criteria?
 |
 |
| A |
B |
 |
 |
| C |
D |
Click
here for the answer to Case 98.
Images
presented in the monthly case studies are from specimens submitted for
diagnosis or archiving. On rare occasions, clinical histories given
may be partly fictitious.
|